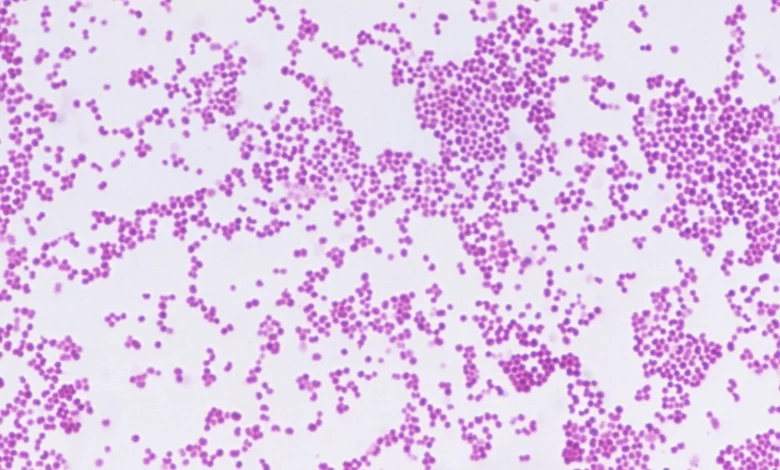

Meningitis Outbreak Kent as campuses and schools respond after two deaths
The meningitis outbreak kent has claimed two young lives and left 11 others seriously ill across a university and three schools, prompting mass antibiotic distribution, contact tracing and disruption to assessments.
What happens next? Scenario mapping and immediate trajectory
Health authorities have taken a containment-first approach: the UK Health Security Agency has shared information with 30, 000 people in the outbreak area, contacts are being traced and offered antibiotics, and long queues formed as students collected medicines on campus. Vaccines are available on the NHS, and charities working on meningitis note the rarity of such clusters but stress the continuing vulnerability of babies, children and young adults.
- Best case: Contact tracing and targeted antibiotic prophylaxis contain transmission quickly. No further deaths occur, hospital admissions fall, and the immediate disruption to exams and campus life remains temporary.
- Most likely: A limited cluster persists in the outbreak area but wider spread is prevented by antibiotics to contacts and outreach by health teams. Some students and pupils move assessments online and the campus remains quieter while cases are monitored.
- Most challenging: Additional cases emerge among close social contacts or in shared accommodation, increasing hospital admissions and extending disruption to teaching and examinations beyond current adjustments.
These scenarios are constrained by current actions already in place: antibiotic offers to known contacts, outreach to tens of thousands in the area, and on-campus medicine distribution. The balance between containment and further transmission will hinge on the speed of contact tracing, uptake of prophylaxis and the effectiveness of targeted communications to students and families.
Meningitis Outbreak Kent: Who wins, who loses?
Immediate winners from a rapid public-health response are the contacts reached and treated early; offering antibiotics reduces the chance that the cluster will grow. Institutions coordinating that response — school and university health teams alongside national health agencies — are positioned to limit harm if tracing remains comprehensive.
Those most at risk remain young people in close social settings and shared accommodation: the outbreak in Canterbury and nearby towns highlights that bacterial meningitis spreads more readily within college and school communities, and that the social scene can increase exposure. Charitable and clinical voices underline that while vaccines have reduced disease over time, sudden clusters can still have devastating effects. Dr Tom Nutt, chief executive of Meningitis Now, said the cluster is shocking and unusual given vaccine availability on the NHS.
Families and classmates are clearly among the hardest hit. A sixth-form pupil from Queen Elizabeth’s grammar school in Faversham was mourned by staff and described by the headteacher, Amelia McIlroy, as kind and intelligent. At the University of Kent, students formed long queues for antibiotics and many wore face masks; teaching for the term has finished and around 1, 700 students had assessments moved online to limit further disruption. MP Helen Whately expressed deep sadness for the young lives lost in the area.
What to expect and what to do next
Expect continued contact tracing, targeted antibiotic offers to those identified as contacts, and local adjustments to teaching and assessment where needed. The clinical profile in this cluster is bacterial meningitis: an infection that causes swelling of the membranes lining the brain and spinal cord, can be life-threatening, and carries risks of brain or nerve damage and blood infection leading to sepsis. In England, roughly 300 to 400 people each year get bacterial meningitis, and for those affected the illness can be horrific.
If you are contacted as a possible contact, taking the antibiotic offer is the immediate protective step being used in this response. Institutions are already moving assessments online where required and keeping campuses open but quieter. Community-level reassurance comes from prompt public-health action and the availability of vaccines the NHS, but the emotional and practical impact on families, classmates and staff will continue while hospital admissions and investigations proceed.
Readers should follow official outreach from health teams, accept antibiotics if offered after contact tracing, and seek urgent clinical advice if meningitis symptoms develop. The region will remain under close local and national public-health scrutiny as agencies continue tracing and treatment in response to the meningitis outbreak kent





